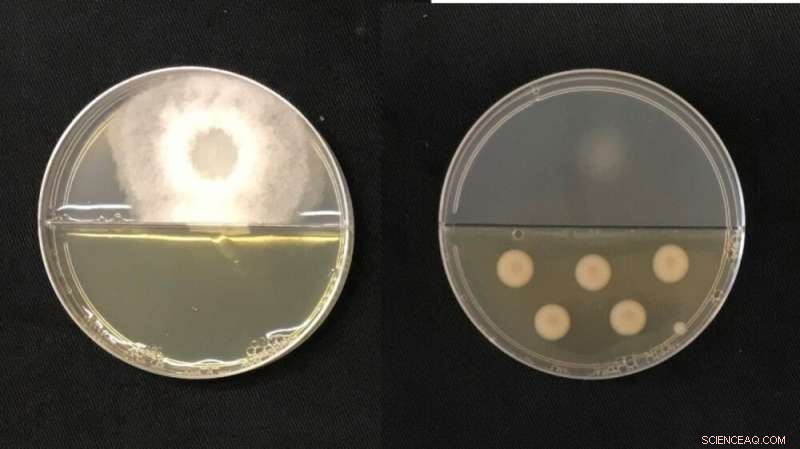
Sugarcane Disease Breakthrough: Bacteria Combat Yield-Reducing Fungus

In the image on the left, the fungus Thielaviopsis ethacetica is growing without contact with the bacterial volatile organic compounds (VOCs). On the right, fungal growth (top) has been inhibited by the bacteria (bottom) that produce the VOCs. Credit: Juliana Velasco de Castro Oliveira/CNPEM
A study conducted at the Brazilian Center for Research in Energy and Materials (CNPEM) has discovered that three strains of Pseudomonas bacteria can inhibit growth, and even cause the death, of the fungus responsible for pineapple sett rot, a disease that attacks sugarcane, especially in the planting season.
The results are reported in an article published in Environmental Microbiology, a journal of the United Kingdom's Society for Applied Microbiology, and could serve as a basis for the development of biological fungicides as an alternative to the chemical pesticides currently used to combat the disease.
The three strains of Pseudomonas were found to inhibit in vitro up to 80% of the mycelial growth of Thielaviopsis ethacetica, a fungus that lives in the soil and penetrates sugarcane stalks through cuts or wounds. The disease can reduce budding and hence yield by as much as 50%. Mycelia are a mass of branched tubular filaments (hyphae) resembling a root system, through which fungi absorb nutrients from the environment.
The bacteria produced 62 volatile organic compounds (VOCs), which downregulated genes relating to the carbohydrate metabolism essential to fungal growth. VOCs are major metabolic products of bacteria and may be liquid or gaseous, easily evaporating at room temperature. Among their advantages is the capacity to travel long distances if applied to crops.
"We saw for the first time that the molecule acts directly or indirectly on the pathogen's DNA, causing damage to the fungus. It's a compound that disrupts the fungal DNA. This kind of molecule isn't investigated much in Brazil. Our aim is to build strength in this research line and become a leading source of knowledge about such molecules in our country," Juliana Velasco de Castro Oliveira, last author of the article, told Agência FAPESP. She is a researcher at CNPEM's Brazilian Biorenewables National Laboratory (LNBR).
Through transcriptomic analysis of the fungal response to VOCs, in which they identified and quantified the expression of new or previously known genes, as well as examination by electron microscopy, the scientists detected changes in the expression of important genes and critical morphological alterations to mycelia treated with VOCs, proving that they hampered fungal growth and could even lead to cell death.
"We were able to find bacterial strains that efficiently controlled this fungus, which causes major damage to sugarcane plantations," Oliveira said. "We also identified molecules that hadn't been described as being capable of killing the fungus, and we proved that they damage its DNA, a property little documented in the literature."
Pineapple sett rot is a disease that affects several tropical crops, but in Brazil has a significant impact on sugarcane yields. The fungus prevents cuttings (or setts, cane segments that sprout to form new stalks) from germinating or developing completely, destroying portions of a plantation. As the fungus reproduces inside the plant, the stem fibers redden, gradually darkening and becoming covered with spores. The fermentation triggered by the pathogen releases a pineapple-like odor.
The incidence of the disease has increased in recent years, and it is now among the most frequent in canefields. Brazil is the world's leading grower of sugarcane. In the 2020-21 crop year, it harvested 654.5 million metric tons, from which it produced 41.2 million tons of sugar and 29.7 billion liters of ethanol.
Crop management techniques such as seedling selection and good tillage can help prevent pineapple sett rot, but agrochemicals are required to control infection, and these can be hazardous to the environment and human health unless they are applied with care.
"Brazil is an agricultural powerhouse," Oliveira said. "We know chemical pesticides can't yet be fully replaced by biological alternatives, but with more research like ours the supply of these could increase on the market, become sustainable alternatives, and help reduce Brazil's reliance on imports."
Every year Brazil imports more than 330,000 metric tons of insecticides, herbicides and fungicides, according to data from the Economy Ministry. Moreover, at least 1,500 new pesticides were authorized for use by growers between 2019 and 2021.
New technologies
The researchers began by screening the 7,000-odd bacteria from different kinds of soil and roots in LNBR's microorganism collection. They selected 70 bacteria belonging to several genera and from different parts of Brazil, such as Tocantins, Mato Grosso and São Paulo states. This sample was submitted to in vitro trials to assess the capacity of the bacteria to inhibit growth of the fungus. The three strains of Pseudomonas identified as most effective in this regard were confirmed by genetic sequencing.
They have now embarked on a new phase with the aim of discovering the species to which the strains belong. "We know they're different, but we don't yet feel sure about identifying the species," Oliveira said. "To arrive at a definition, we must perform whole-genome sequencing of these bacteria. In fact, we've already noted that one must be from a species that has yet to be described. We'll attempt to describe it shortly, in partnership with UNICAMP [the University of Campinas in São Paulo]."
Scientists affiliated with UNICAMP's Program of Graduate Studies in Genetics and Molecular Biology and the Federal University of Lavras (UFLA) in Minas Gerais state are participating in the research group. "It's impossible to do research on your own these days, especially when you're exploring a new area. Collaboration is important to combine different kinds of expertise," she explained.
At CNPEM's Brazilian Synchrotron Light Laboratory (LNLS), which operates Sirius, Brazil's fourth-generation particle accelerator, spectroscopic analysis confirmed the biomolecules' ability to damage the fungal DNA. Infrared light and other highly sensitive techniques were used to reveal this property of the biomolecules.
In addition, severe morphological alterations to the mycelia were highlighted by means of transmission and scanning microscopy at CNPEM's Brazilian Nanotechnology National Laboratory (LNNano).